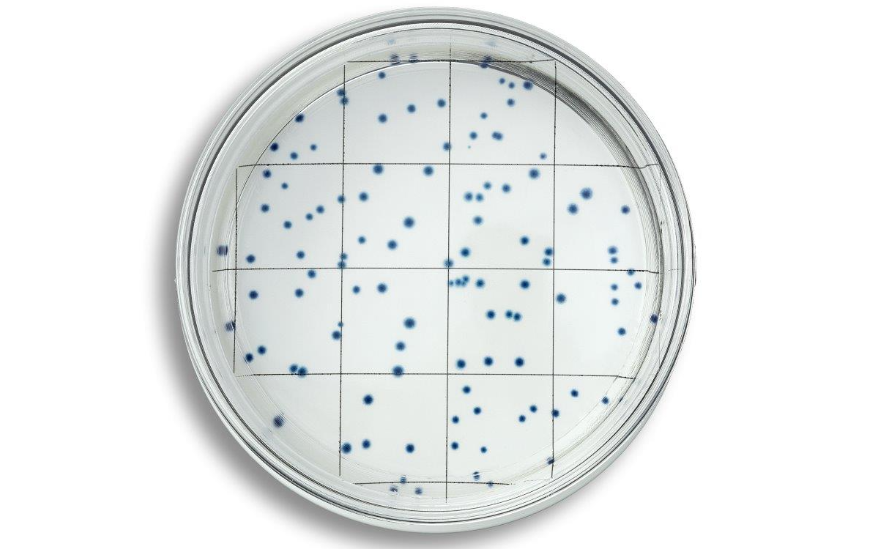

Easydisc PCA 平皿法检测菌落总数
EasyDisc PCA
- WPCA100
- IDEXX
- 上海市
- 现货
- 按需定制
- 议价
- 2022-05-30 17:54:11
爱德士缅因生物制品贸易(上海)有限公司
一键申请试用
咨询
加入意向单
联系方式
- 英文名称
- EasyDisc PCA
- 关键词
- 平皿法检测菌落总数国标方法菌落总数cfu法无需无菌室
- 包装
- 100个含培养基皿/包
- 小包装
- 25个含培养基平皿/包
Easydisc PCA 平皿法检测菌落总数
*无需在专业无菌室内操作
*无需设备、无需高压灭菌、无需配置培养基
*在36±1℃培养48小时即可得到cfu/mL结果
*蓝色菌落易于判读,等同于国标的平皿倾注法
EasyDisc PCA检测原理:
EasyDisc PCA 方法用于可培养的、水传播细菌的定量检测。可培养的是指在固体培养基上能形成菌落的任何需氧细菌。它是基于比色技术,通过检测生长情况和已知存在于这些生物体中的关键酶来检测活性的需氧菌或兼性厌氧菌。它使用被大多数水传播细菌代谢时产生蓝色反应的底物。将样本直接加到 EasyDisc PCA 平皿上,培养,然后检查蓝色菌落。
EasyDisc PCA检测菌落总数特点:
*操作简单,避免浪费并改进了工作流程
*12月保质期,避免浪费并改进了工作流程
*操作简单,手工时间少于1分钟
*减少质量控制环节
*两种产品规格:25皿培养基/包和100皿培养基/包
EasyDisc PCA检测菌落总数操作说明:
第 1 步 取下盖子,向EasyDisc PCA平皿中加入1mL水样
第 2 步 轻轻旋转平皿使液体分布整个平皿,盖上盖子,在室温下静置20分钟
第 3 步 在36±1℃培养48小时
第 4 步 数出蓝色菌落

更多产品信息请联系:IDEXX 爱德士公司